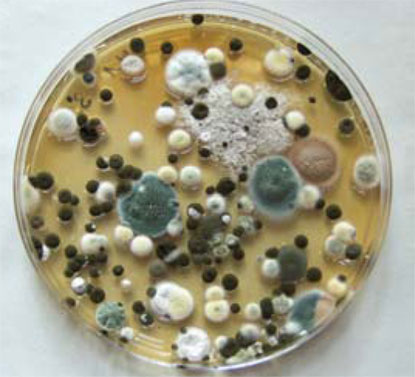
Mold spores on surfaces resulting from poor indoor air quality

Asthma triggers are commonly found in homes, schools,
and offices and include mold, dust mites, secondhand
smoke, and pet dander. A home may have mold growing on
a shower curtain, dust mites in pillows, blankets or stuffed
animals, secondhand smoke in the air, and cat and dog
hairs on the carpet or floors. Other common asthma triggers
include some foods and pollutants in the air. These items can be removed from the air by installing a whole house air cleaning system. A simple filter is not enough and will not stop these pollutants from taking over your household. Give us a call , or better yet, print out the coupon for a full system $39 tune up and let us evaluate your entire system to see if your home air conditioner and heater is adding to the level of indoor air pollution in your home. Asthma triggers are commonly found in homes, schools,
and offices and include mold, dust mites, secondhand
smoke, and pet dander. A home may have mold growing on
a shower curtain, dust mites in pillows, blankets or stuffed
animals, secondhand smoke in the air, and cat and dog
hairs on the carpet or floors. Other common asthma triggers
include some foods and pollutants in the air. These items can be removed from the air by installing a whole house air cleaning system. A simple filter is not enough and will not stop these pollutants from taking over your household. Give us a call , or better yet, print out the coupon for a full system $39 tune up and let us evaluate your entire system to see if your home air conditioner and heater is adding to the level of indoor air pollution in your home.
Asthma triggers cause symptoms including coughing,
chest tightness, wheezing, and breathing problems. An
asthma attack occurs when symptoms keep getting worse
or are suddenly very severe. Asthma attacks can be life
threatening. However, asthma is controllable with the
right medicines and by reducing asthma triggers. The American Standard AccuClean and the IQAir Perfect 16 Whole house cleaning systems are the leading examples of whole house air cleaners that can remove these asthma triggers from the air your breathe. Give us a call and ask for us to test for these asthma triggers in your home.
 Molds are living things that produce spores. Molds produce
spores that float in the air, land on damp surfaces, and grow.
Inhaling or touching molds can cause hay fever-type
symptoms such as sneezing, runny nose, red eyes, and
skin rashes. Molds can also trigger asthma attacks. Molds are living things that produce spores. Molds produce
spores that float in the air, land on damp surfaces, and grow.
Inhaling or touching molds can cause hay fever-type
symptoms such as sneezing, runny nose, red eyes, and
skin rashes. Molds can also trigger asthma attacks.
Take steps to help improve your air quality and reduce your
IAQ-related health risks at little or no cost by:
Controlling the sources of pollution: Usually the
most effective way to improve indoor air is to eliminate
individual sources or reduce their emissions.
Ventilating: Increasing the amount of fresh air brought
indoors helps reduce pollutants inside. When weather
permits, open windows and doors, or run an air conditioner  with a whole house cleaning system installed
with the vent control open. Bathroom and kitchen fans that
exhaust to the outdoors also increase ventilation and help
remove indoor air pollutants.
Always ventilate and follow manufacturers’ instructions
when you use products or appliances that may re with a whole house cleaning system installed
with the vent control open. Bathroom and kitchen fans that
exhaust to the outdoors also increase ventilation and help
remove indoor air pollutants.
Always ventilate and follow manufacturers’ instructions
when you use products or appliances that may re lease pollutants into the indoor air. lease pollutants into the indoor air.
Changing air cleaning filtration media regularly: Central heaters and air
conditioners have filters to trap dust and other pollutants in
the air. Make sure to have your heating and air conditioning system regularly checked out by a qualified air conditioning and heating contractor.
Adjusting humidity: The humidity inside can affect the
concentrations of some indoor air pollutants.
 Call us to your home and ask for a free indoor particle scan. We can tell scientifically find the number of particles between .01 microns and 30 microns, the harmful size, that are floating around in the air of your home. We can then show you exactly what the AccuClean air cleaning system can do for you and your family. It’s time to stop suffering from allergies, asthma and other lung ailments that poor indoor air can aggravate. Call us to your home and ask for a free indoor particle scan. We can tell scientifically find the number of particles between .01 microns and 30 microns, the harmful size, that are floating around in the air of your home. We can then show you exactly what the AccuClean air cleaning system can do for you and your family. It’s time to stop suffering from allergies, asthma and other lung ailments that poor indoor air can aggravate.

Read More Testimonials
 I was impressed with his attention to detail and his concern that everything be just right. I was impressed with his attention to detail and his concern that everything be just right.
~ Elaine Suguyania
 ......Thanks for calling to inform us of your arrival time. ......Thanks for calling to inform us of your arrival time. 
~ Dennis Barry
 ..was very happy with service and gave good advice on future needs. ..was very happy with service and gave good advice on future needs. 
~ Maxine Spees
|

Asthma triggers are commonly found in homes, schools,
and offices and include mold, dust mites, secondhand
smoke, and pet dander. A home may have mold growing on
a shower curtain, dust mites in pillows, blankets or stuffed
animals, secondhand smoke in the air, and cat and dog
hairs on the carpet or floors. Other common asthma triggers
include some foods and pollutants in the air. These items can be removed from the air by installing a whole house air cleaning system. A simple filter is not enough and will not stop these pollutants from taking over your household. Give us a call , or better yet, print out the coupon for a full system $39 tune up and let us evaluate your entire system to see if your home air conditioner and heater is adding to the level of indoor air pollution in your home.
Asthma triggers are commonly found in homes, schools,
and offices and include mold, dust mites, secondhand
smoke, and pet dander. A home may have mold growing on
a shower curtain, dust mites in pillows, blankets or stuffed
animals, secondhand smoke in the air, and cat and dog
hairs on the carpet or floors. Other common asthma triggers
include some foods and pollutants in the air. These items can be removed from the air by installing a whole house air cleaning system. A simple filter is not enough and will not stop these pollutants from taking over your household. Give us a call , or better yet, print out the coupon for a full system $39 tune up and let us evaluate your entire system to see if your home air conditioner and heater is adding to the level of indoor air pollution in your home.
 Molds are living things that produce spores. Molds produce
spores that float in the air, land on damp surfaces, and grow.
Inhaling or touching molds can cause hay fever-type
symptoms such as sneezing, runny nose, red eyes, and
skin rashes. Molds can also trigger asthma attacks.
Molds are living things that produce spores. Molds produce
spores that float in the air, land on damp surfaces, and grow.
Inhaling or touching molds can cause hay fever-type
symptoms such as sneezing, runny nose, red eyes, and
skin rashes. Molds can also trigger asthma attacks. with a whole house cleaning system installed
with the vent control open. Bathroom and kitchen fans that
exhaust to the outdoors also increase ventilation and help
remove indoor air pollutants.
Always ventilate and follow manufacturers’ instructions
when you use products or appliances that may re
with a whole house cleaning system installed
with the vent control open. Bathroom and kitchen fans that
exhaust to the outdoors also increase ventilation and help
remove indoor air pollutants.
Always ventilate and follow manufacturers’ instructions
when you use products or appliances that may re lease pollutants into the indoor air.
lease pollutants into the indoor air. Call us to your home and ask for a free indoor particle scan. We can tell scientifically find the number of particles between .01 microns and 30 microns, the harmful size, that are floating around in the air of your home. We can then show you exactly what the AccuClean air cleaning system can do for you and your family. It’s time to stop suffering from allergies, asthma and other lung ailments that poor indoor air can aggravate.
Call us to your home and ask for a free indoor particle scan. We can tell scientifically find the number of particles between .01 microns and 30 microns, the harmful size, that are floating around in the air of your home. We can then show you exactly what the AccuClean air cleaning system can do for you and your family. It’s time to stop suffering from allergies, asthma and other lung ailments that poor indoor air can aggravate.
